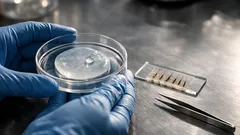
Neuer Haarwuchs durch Zucker-Molekül? Was die 2dDR-Studie 2024 wirklich zeigt

Vorgeschlagene Artikel

Lifehacks & Alltagstipps
WC-Papier im Kühlschrank: hilft das wirklich gegen Gerüche und Eis?

Lifehacks & Alltagstipps
Umzug mit Hund: 5 Schritte, damit er nicht entläuft

Lifehacks & Alltagstipps
Katzengedächtnis: so erinnern sich Katzen an Menschen, Orte und Gefühle

Lifehacks & Alltagstipps
Studie: manche Hunde verstehen Wörter nach Funktion – was das für Spielen und Training bedeutet

Stress & Resilienz
Frische Schnittblumen im Alltag: wie sie Stimmung heben und Stress spürbar senken können

Stress & Resilienz
Ungewissheit aushalten: 4 Strategien, die Stress sofort senken

Regionale Kultur & Brauchtum
Neue Studie: die ältesten Mumien könnten aus Südchina stammen – konserviert durch Rauch

Gesundheit im Alltag
Rauchstopp ab 50: wie Aufhören Gedächtnis und Wortfindung messbar schützen kann

Regionale Kultur & Brauchtum
Frühmittelalterliche Grabhügel bei Sizewell C entdeckt: Elitegrab mit Pferd und Waffen

Gesundheit im Alltag
Winter und Atemwege: so hilft dir das richtige Raumklima gegen trockenen Hals

Lifehacks & Alltagstipps
Warum wir am Zebrastreifen winken und was das im Stadtverkehr wirklich bringt

Lifehacks & Alltagstipps
WC-Papier im Kühlschrank: hilft das wirklich gegen Gerüche und Eis?

Ernährung & Küche
Alufolie: welche Seite gehört ans Essen – glänzend oder matt?

Lifehacks & Alltagstipps
Parkett reinigen ohne Schlieren: so wischst du nebelfeucht und schonend

Lifehacks & Alltagstipps
Stuhlkissen nähen: einfache Anleitung für einen waschbaren Bezug

Gesundheit im Alltag
Bill Gates warnt: warum globale Gesundheit 2026 kippen könnte – und was KI damit zu tun hat
Gesundheit im Alltag
Kommentare